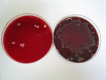

Bacterial contamination of endoscopist and assistant face visors during gastrointestinal endoscopy: a pilot study
- PMID: 37854781
- PMCID: PMC10579546
- DOI: 10.1136/flgastro-2023-102427
Bacterial contamination of endoscopist and assistant face visors during gastrointestinal endoscopy: a pilot study
Abstract
Background and aim: During the COVID-19 pandemic, health workers' facial exposure to pathogens has been brought into focus. In this study, we aimed to determine the occurrence and degree of facial contamination to both endoscopists and their assistants during endoscopic procedures to help inform future safety measures.
Methods: Non-sterile visors worn by endoscopist, assistant and room control visors from 50 procedures were swabbed post procedure for culture. Procedure type, therapy, duration and evidence of visible visor contamination were recorded. After 48-hour incubation, all bacterial colonies were identified using matrix-assisted laser desorption/ionisation time-of-flight mass spectrometry. Organisms were classified into skin/environmental, oronasal and enteric.
Results: A total of 104 visors were available for assessment (93 staff; 11 control). In worn visors, skin/environmental flora were isolated from 70, oronasal flora from 8, and enteric flora from 3 with an average colony count of >9.5. Notably, bacteria of enteric origin (Escherichia coli and Enterobacter cloacae) were isolated from three worn visors. In room control, skin/environmental flora were isolated from seven and oronasal flora from one with average colony count of five. No room control visors grew enteric flora. Overall, 9.1% room control and 10.8% worn visors were contaminated with organisms that could possibly have originated from patients. However, enteric flora were only obtained from worn visors. No visors were visibly contaminated.
Conclusion: This pilot study demonstrates risk of contamination to faces of endoscopists and assistants. Larger studies are required to determine degree of risk and to give guidance on facial protection during gastrointestinal endoscopy.
Keywords: diagnostic and therapeutic endoscopy; gastrointesinal endoscopy; intestinal bacteria.
© Author(s) (or their employer(s)) 2023. No commercial re-use. See rights and permissions. Published by BMJ.
Conflict of interest statement
Competing interests: None declared.
Figures

References
-
- 2020 guidance on decontamination of equipment for gastrointestinal endoscopy. n.d. Available: https://www.bsg.org.uk/clinical-resource/guidance-on-decontamination-of-...
LinkOut - more resources
Full Text Sources
